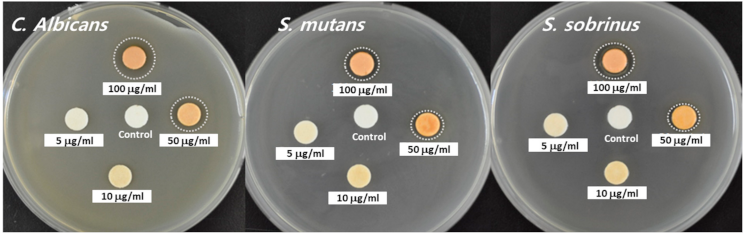
Materials 14 01193 g005 Materials 14 01193 g005

Antibacterial Activity of Propolis-Embedded Zeolite Nanocomposites for Implant Application
Abstract
1. Introduction
2. Materials and Methods
2.1. Materials
2.2. Fabrication of Propolis-Embedded Zeolite Nanocomposite
2.3. Characterization of Propolis-Embedded Zeolite Nanocomposites
2.4. Preparation of PLA/PCL Pellets and Dental Implants
2.5. Antibacterial Activity Study
2.6. Cell Culture
3. Results
3.1. Fabrication and Characterization of Zeolite Nanocomposites
3.2. Fabrication of PLA/PCL Pellets Complexed with Propolis-Embedded Nanocomposites and Drug Release
3.3. Antibacterial Activity
3.4. Biological Activity of Dental Implant Fabricated from Propolis-Embedded Zeolite Nanocomposite and PLA/PCL Polymer
4. Discussion
5. Conclusions
Supplementary Materials
Author Contributions
Funding
Institutional Review Board Statement
Informed Consent Statement
Data Availability Statement
Conflicts of Interest
References
- Danhier, F.; Ansorena, E.; Silva, J.M.; Coco, R.; Le Breton, A.; Préat, V. PLGA-based nanoparticles: An overview of biomedical applications. J. Control. Release 2012, 161, 505–522. [Google Scholar] [CrossRef] [PubMed]
- Kim, Y.J.; Jeong, B. Graphene-Based Nanomaterials and Their Applications in Biosensors. Adv. Exp. Med. Biol. 2018, 1064, 61–71. [Google Scholar] [PubMed]
- Choi, G.E.; Kang, M.S.; Kim, Y.J.; Yoon, J.J.; Jeong, Y.I. Magnetically Responsive Drug Delivery Using Doxorubicin and Iron Oxide Nanoparticle-Incorporated Lipocomplexes. J. Nanosci. Nanotechnol. 2019, 19, 675–679. [Google Scholar] [CrossRef]
- Daraee, H.; Eatemadi, A.; Abbasi, E.; Fekri, A.S.; Kouhi, M.; Akbarzadeh, A. Application of gold nanoparticles in biomedical and drug delivery. Artif. Cells. Nanomed. Biotechnol. 2016, 44, 410–422. [Google Scholar] [CrossRef]
- Ogawa, T.; Iyoki, K.; Fukushima, T.; Kajikawa, Y. Landscape of research areas for zeolites and metal-organic frameworks using computational classification based on citation networks. Materials 2017, 10, 1428. [Google Scholar] [CrossRef] [PubMed]
- Derakhshankhah, H.; Jafari, S.; Sarvari, S.; Barzegari, E.; Moakedi, F.; Ghorbani, M.; Shiri Varnamkhasti, B.; Jaymand, M.; Izadi, Z.; Tayebi, L. Biomedical Applications of Zeolitic Nanoparticles, with an emphasis on Medical Interventions. Int. J. Nanomed. 2020, 15, 363–386. [Google Scholar] [CrossRef]
- Shashirekha, G.; Jena, A.; Mohapatra, S. Nanotechnology in Dentistry: Clinical Applications, Benefits, and Hazards. Compend. Contin. Educ. Dent. 2017, 38, e1–e4. [Google Scholar]
- Anggani, H.S.; Perdana, R.G.; Siregar, E.; Bachtiar, E.W. The effect of coating chitosan on Porphyromonas gingivalis biofilm formation in the surface of orthodontic mini-implant. J. Adv. Pharm. Technol. Res. 2021, 12, 84–88. [Google Scholar] [CrossRef]
- Wang, X.; Fan, H.; Zhang, F.; Zhao, S.; Liu, Y.; Xu, Y.; Wu, R.; Li, D.; Yang, Y.; Liao, L.; et al. Antibacterial properties of bilayer biomimetic nano-ZnO for dental implants. ACS Biomater. Sci. Eng. 2020, 6, 1880–1886. [Google Scholar] [CrossRef]
- Holmberg, K.V.; Abdolhosseini, M.; Li, Y.; Chen, X.; Gorr, S.U.; Aparicio, C. Bio-inspired stable antimicrobial peptide coatings for dental applications. Acta Biomater. 2013, 9, 8224–8231. [Google Scholar] [CrossRef]
- Kyzioł, K.; Kaczmarek, Ł.; Kyzioł, A. Surface Functionalization of Biomaterials. In Handbook of Composites from Renewable Materials; Thakur, V.K., Thakur, M.K., Kessler, M.R., Eds.; Wiley: Hoboken, NJ, USA, 2017; Volume 4, pp. 457–490. [Google Scholar]
- Wilson, T.G., Jr. Bone loss around implants-is it metallosis? J. Periodontol. 2021, 92, 181–185. [Google Scholar] [CrossRef] [PubMed]
- Bradberry, S.M.; Wilkinson, J.M.; Ferner, R.E. Systemic toxicity related to metal hip prostheses. Clin. Toxicol. 2014, 52, 837–847. [Google Scholar] [CrossRef] [PubMed]
- Serati-Nouri, H.; Jafari, A.; Roshangar, L.; Dadashpour, M.; Pilehvar-Soltanahmadi, Y.; Zarghami, N. Biomedical applications of zeolite-based materials: A review. Mater. Sci. Eng. C Mater. Biol. Appl. 2020, 116, 111225. [Google Scholar] [CrossRef]
- Kihara, T.; Zhang, Y.; Hu, Y.; Mao, Q.; Tang, Y.; Miyake, J. Effect of composition, morphology and size of nanozeolite on its in vitro cytotoxicity. J. Biosci. Bioeng. 2011, 111, 725–730. [Google Scholar] [CrossRef]
- Maleki, A.; Shahbazi, M.A.; Alinezhad, V.; Santos, H.A. The Progress and Prospect of Zeolitic Imidazolate Frameworks in Cancer Therapy, Antibacterial Activity, and Biomineralization. Adv. Healthc. Mater. 2020, 9, e2000248. [Google Scholar] [CrossRef]
- Maeda, T.; Nosé, Y. A new antibacterial agent: Antibacterial zeolite. Artif. Organs. 1999, 23, 129–130. [Google Scholar] [CrossRef] [PubMed]
- Zhang, W.; Martinelli, J.; Peters, J.A.; van Hengst, J.M.A.; Bouwmeester, H.; Kramer, E.; Bonnet, C.S.; Szeremeta, F.; Tóth, É.; Djanashvili, K. Surface PEG Grafting Density Determines Magnetic Relaxation Properties of Gd-Loaded Porous Nanoparticles for MR Imaging Applications. ACS Appl. Mater. Interfaces 2017, 9, 23458–23465. [Google Scholar] [CrossRef]
- Pan, Y.B.; Wang, S.; He, X.; Tang, W.; Wang, J.; Shao, A.; Zhang, J. A combination of glioma in vivo imaging and in vivo drug delivery by metal-organic framework based composite nanoparticles. J. Mater. Chem. B 2019, 7, 7683–7689. [Google Scholar] [CrossRef]
- Yuan, K.; Chen, K.-C.; Chan, Y.-J.; Tsai, C.-C.; Chen, H.-H.; Shih, C.-C. Dental implant failure associated with bacterial infection and long-term bisphosphonate usage: A case report. Implant. Dent. 2012, 21, 3–7. [Google Scholar] [CrossRef] [PubMed]
- Sun, C.X.; Henkin, J.M.; Ririe, C.; Javadi, E. Implant failure associated with actinomycosis in a medically compromised patient. J. Oral Implantol. 2013, 39, 206–209. [Google Scholar] [CrossRef] [PubMed]
- Esposito, M.; Grusovin, M.G.; Worthington, H.V. Interventions for replacing missing teeth: Antibiotics at dental implant placement to prevent complications. Cochrane Database Syst. Rev. 2013, 2013, CD004152. [Google Scholar] [CrossRef] [PubMed]
- Roy, R.; Tiwari, M.; Donelli, G.; Tiwari, V. Strategies for combating bacterial biofilms: A focus on anti-biofilm agents and their mechanisms of action. Virulence 2018, 9, 522–554. [Google Scholar] [CrossRef] [PubMed]
- Rajeshwari, H.R.; Dhamecha, D.; Jagwani, S.; Rao, M.; Jadhav, K.; Shaikh, S.; Puzhankara, L.; Jalalpure, S. Local drug delivery systems in the management of periodontitis: A scientific review. J. Control. Release 2019, 307, 393–409. [Google Scholar]
- Senel, S.; Kremer, M.; Nagy, K.; Squier, C. Delivery of bioactive peptides and proteins across oral (buccal) mucosa. Curr. Pharm. Biotechnol. 2001, 2, 175–186. [Google Scholar] [CrossRef]
- Mizrahi, B.; Domb, A.J. Mucoadhesive polymers for delivery of drugs to the oral cavity. Recent Pat. Drug Deliv. Formul. 2008, 2, 108–119. [Google Scholar] [CrossRef] [PubMed]
- Steinberg, D.; Friedman, M. Sustained-release drug delivery of antimicrobials in controlling of supragingival oral biofilms. Expert Opin. Drug Deliv. 2017, 14, 571–581. [Google Scholar] [CrossRef]
- Goyal, G.; Garg, T.; Rath, G.; Goyal, A.K. Current nanotechnological strategies for an effective delivery of drugs in treatment of periodontal disease. Crit. Rev. Ther. Drug Carrier Syst. 2014, 31, 89–119. [Google Scholar] [CrossRef]
- Shameli, K.; Ahmad, M.B.; Zargar, M.; Yunus, W.M.; Ibrahim, N.A. Fabrication of silver nanoparticles doped in the zeolite framework and antibacterial activity. Int. J. Nanomed. 2011, 6, 331–341. [Google Scholar] [CrossRef]
- Can, C.; Akca, A.E.; Körlü, A.; Ates, M. Use of silver-loaded zeolites in the antibacterial finishing of cotton fabrics. Tekstil ve Konfeksiyon 2013, 23, 32–37. [Google Scholar]
- Zhang, Y.; Xu, C.; He, Y.; Wang, X.; Xing, F.; Qiu, H.; Liu, Y.; Ma, D.; Lin, T.; Gao, J. Zeolite/polymer composite hollow microspheres containing antibiotics and the in vitro drug release. J. Biomater. Sci. Polym. Ed. 2011, 22, 809–822. [Google Scholar] [CrossRef]
- Song, Z.; Wu, Y.; Cao, Q.; Wang, H.; Wang, X.; Han, H. pH-Responsive, Light-Triggered on-Demand Antibiotic Release from Functional Metal–Organic Framework for Bacterial Infection Combination Therapy. Adv. Funct. Mater. 2018, 28, 1800011. [Google Scholar] [CrossRef]
- Stepanović, S.; Antić, N.; Dakić, I.; Svabić-Vlahović, M. In vitro antimicrobial activity of propolis and synergism between propolis and antimicrobial drugs. Microbiol. Res. 2003, 158, 353–357. [Google Scholar] [CrossRef]
- Przybyłek, I.; Karpiński, T.M. Antibacterial Properties of Propolis. Molecules 2019, 24, 2047. [Google Scholar] [CrossRef] [PubMed]
- Wojtyczka, R.D.; Dziedzic, A.; Idzik, D.; Kępa, M.; Kubina, R.; Kabała-Dzik, A.; Smoleń-Dzirba, J.; Stojko, J.; Sajewicz, M.; Wąsik, T.J. Susceptibility of Staphylococcus aureus clinical isolates to propolis extract alone or in combination with antimicrobial drugs. Molecules 2013, 18, 9623–9640. [Google Scholar] [CrossRef] [PubMed]
- Jahangirian, H.; Rafiee-Moghaddam, R.; Jahangirian, N.; Nikpey, B.; Jahangirian, S.; Bassous, N.; Saleh, B.; Kalantari, K.; Webster, T.J. Green Synthesis of Zeolite/Fe(2)O(3) Nanocomposites: Toxicity & Cell Proliferation Assays and Application as a Smart Iron Nanofertilizer. Int. J. Nanomed. 2020, 15, 1005–1020. [Google Scholar]
- Cao, Y.; Jiang, Z.; Li, Y.; Wang, Y.; Yang, Y.; Akakuru, O.U.; Li, J.; Wu, A. Tandem post-synthetic modification of a zeolitic imidazolate framework for CXCR4-overexpressed esophageal squamous cell cancer imaging and therapy. Nanoscale 2020, 12, 12779–12789. [Google Scholar] [CrossRef]
- Chen, H.; Yang, J.; Sun, L.; Zhang, H.; Guo, Y.; Qu, J.; Jiang, W.; Chen, W.; Ji, J.; Yang, Y.W.; et al. Synergistic chemotherapy and photodynamic therapy of endophthalmitis mediated by zeolitic imidazolate framework-based drug delivery systems. Small 2019, 15, e1903880. [Google Scholar] [CrossRef] [PubMed]
- Sava Gallis, D.F.; Butler, K.S.; Agola, J.O.; Pearce, C.J.; McBride, A.A. Antibacterial Countermeasures via Metal-Organic Framework-Supported Sustained Therapeutic Release. ACS Appl. Mater. Interfaces 2019, 11, 7782–7791. [Google Scholar] [CrossRef] [PubMed]
- Bedi, R.S.; Beving, D.E.; Zanello, L.P.; Yan, Y. Biocompatibility of corrosion-resistant zeolite coatings for titanium alloy biomedical implants. Acta Biomater. 2009, 5, 3265–3271. [Google Scholar] [CrossRef] [PubMed]
- Khurshid, Z.; Naseem, M.; Zafar, M.S.; Najeeb, S.; Zohaib, S. Propolis: A natural biomaterial for dental and oral healthcare. J. Dent. Res. Dent. Clin. Dent. Prospects 2017, 11, 265–274. [Google Scholar]
- Halboub, E.; Al-Maweri, S.A.; Al-Wesabi, M.; Al-Kamel, A.; Shamala, A.; Al-Sharani, A.; Koppolu, P. Efficacy of propolis-based mouthwashes on dental plaque and gingival inflammation: A systematic review. BMC Oral Health 2020, 20, 198. [Google Scholar] [CrossRef] [PubMed]
- Santiago, K.B.; Piana, G.M.; Conti, B.J.; Cardoso, E.O.; Murbach Teles Andrade, B.F.; Zanutto, M.R.; Mores Rall, V.L.; Fernandes, A., Jr.; Sforcin, J.M. Microbiological control and antibacterial action of a propolis-containing mouthwash and control of dental plaque in humans. Nat. Prod. Res. 2018, 32, 1441–1445. [Google Scholar] [CrossRef] [PubMed]
- Ambi, A.; Bryan, J.; Borbon, K.; Centeno, D.; Liu, T.; Chen, T.P.; Cattabiani, T.; Traba, C. Are Russian propolis ethanol extracts the future for the prevention of medical and biomedical implant contaminations? Phytomedicine 2017, 30, 50–58. [Google Scholar] [CrossRef] [PubMed]
- de Souza, R.F.; Silva-Lovato, C.H.; de Arruda, C.N.; Regis, R.R.; Zanini, A.P.; Longo, D.L.; Peracini, A.; de Andrade, I.M.; Watanabe, E.; Paranhos, H.F. Efficacy of a propolis solution for cleaning complete dentures. Am. J. Dent. 2019, 32, 306–310. [Google Scholar]
- Afrasiabi, S.; Pourhajibagher, M.; Chiniforush, N.; Bahador, A. Propolis nanoparticle enhances the potency of antimicrobial photodynamic therapy against Streptococcus mutans in a synergistic manner. Sci. Rep. 2020, 10, 15560. [Google Scholar] [CrossRef]
- Marquele-Oliveira, F.; da Silva Barud, H.; Torres, E.C.; Machado, R.T.A.; Caetano, G.F.; Leite, M.N.; Frade, M.A.C.; Ribeiro, S.J.L.; Berretta, A.A. Development, characterization and pre-clinical trials of an innovative wound healing dressing based on propolis (EPP-AF)-containing self-microemulsifying formulation incorporated in biocellulose membranes. Int. J. Biol. Macromol. 2019, 136, 570–578. [Google Scholar] [CrossRef] [PubMed]
- Franca, J.R.; De Luca, M.P.; Ribeiro, T.G.; Castilho, R.O.; Moreira, A.N.; Santos, V.R.; Faraco, A.A. Propolis—based chitosan varnish: Drug delivery, controlled release and antimicrobial activity against oral pathogen bacteria. BMC Complement. Altern. Med. 2014, 14, 478. [Google Scholar] [CrossRef]
- Gulías, Ò.; McKenzie, G.; Bayó, M.; Agut, M.; Nonell, S. Effective photodynamic inactivation of 26 Escherichia coli strains with different antibiotic susceptibility profiles: A Planktonic and biofilm study. Antibiotics 2020, 9, 98. [Google Scholar] [CrossRef] [PubMed]
- Surek, M.; Fachi, M.M.; de Fátima Cobre, A.; de Oliveira, F.F.; Pontarolo, R.; Crisma, A.R.; de Souza, W.M.; Felipe, K.B. Chemical composition, cytotoxicity, and antibacterial activity of propolis from Africanized honeybees and three different Meliponini species. J. Ethnopharmacol. 2021, 269, 113662. [Google Scholar] [CrossRef] [PubMed]
- Amalia, E.; Diantini, A.; Subarnas, A. Water-soluble propolis and bee pollen of Trigona spp. from South Sulawesi Indonesia induce apoptosis in the human breast cancer MCF-7 cell line. Oncol. Lett. 2020, 20, 274. [Google Scholar] [CrossRef]
- Dastan, F.; Ameri, A.; Dodge, S.; Hamidi Shishvan, H.; Pirsalehi, A.; Abbasinazari, M. Efficacy and safety of propolis mouthwash in management of radiotherapy induced oral mucositis; A randomized, double blind clinical trial. Rep. Pract. Oncol. Radiother 2020, 25, 969–973. [Google Scholar] [CrossRef] [PubMed]

| Concentration (μg/mL) | Inhibition Clear Zone (Diameter, mm) | |
|---|---|---|
| Powder | Cotton Swab | |
| 1 | 1 | 0.7 |
| 2 | 1.1 | 0.5 |
| 3 | - | - |
| Concentration (μg/mL) | Inhibition Clear Zone (Diameter, mm) | ||
|---|---|---|---|
| C. albicans | S. mutans | S. sobrinus | |
| Control | - | - | - |
| 5 | - | - | - |
| 10 | - | - | - |
| 50 | 2 | 1 | 1 |
| 100 | 3.5 | 1.5 | 2 |
Publisher’s Note: MDPI stays neutral with regard to jurisdictional claims in published maps and institutional affiliations. |
© 2021 by the authors. Licensee MDPI, Basel, Switzerland. This article is an open access article distributed under the terms and conditions of the Creative Commons Attribution (CC BY) license (http://creativecommons.org/licenses/by/4.0/).
Share and Cite
Son, J.S.; Hwang, E.J.; Kwon, L.S.; Ahn, Y.-G.; Moon, B.-K.; Kim, J.; Kim, D.H.; Kim, S.G.; Lee, S.-Y. Antibacterial Activity of Propolis-Embedded Zeolite Nanocomposites for Implant Application. Materials 2021, 14, 1193. https://doi.org/10.3390/ma14051193
Son JS, Hwang EJ, Kwon LS, Ahn Y-G, Moon B-K, Kim J, Kim DH, Kim SG, Lee S-Y. Antibacterial Activity of Propolis-Embedded Zeolite Nanocomposites for Implant Application. Materials. 2021; 14(5):1193. https://doi.org/10.3390/ma14051193
Chicago/Turabian StyleSon, Jun Sik, Eun Ju Hwang, Lee Seong Kwon, Yong-Gook Ahn, Byung-Kwon Moon, Jin Kim, Douk Hoon Kim, Su Gwan Kim, and Sook-Young Lee. 2021. "Antibacterial Activity of Propolis-Embedded Zeolite Nanocomposites for Implant Application" Materials 14, no. 5: 1193. https://doi.org/10.3390/ma14051193
APA StyleSon, J. S., Hwang, E. J., Kwon, L. S., Ahn, Y.-G., Moon, B.-K., Kim, J., Kim, D. H., Kim, S. G., & Lee, S.-Y. (2021). Antibacterial Activity of Propolis-Embedded Zeolite Nanocomposites for Implant Application. Materials, 14(5), 1193. https://doi.org/10.3390/ma14051193

